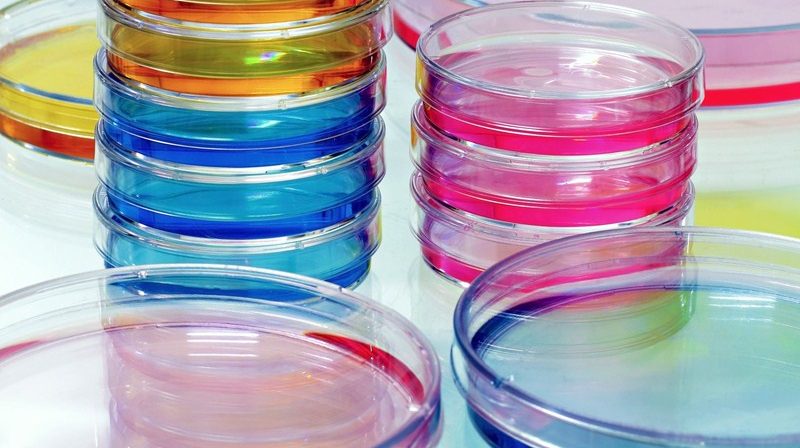
Update on proposed coronavirus

Update on proposed coronavirus – related SSP changes
Firstly, the Statutory Sick Pay (General) (Coronavirus Amendment) Regulations 2020 have amended the Statutory Sick Pay (General) Regulations 1982, to include, in the definition of persons deemed incapable of work for the purposes of SSP entitlement, those who are isolating themselves from other people in such a manner as to prevent infection or contamination with coronavirus, in accordance with guidance published by Public Health England, Public Health Wales or NHS National Services Scotland, and who by reason of that isolation are unable to work.
The regulations came into force on 13 March 2020, are to be kept under review by the government and, in any event, will cease to have effect eight months after they came into force. Note that the amendment here would not include those who are working from home during self-isolation, as those individuals are still able to work and are working. Neither would it include those who choose to self-isolate because they are concerned about catching the virus, if their self-isolation isn’t in accordance with the latest published guidance.
Secondly, the Chancellor announced in the Spring Budget on 11 March 2020 that, as a special temporary measure, employers with fewer than 250 employees will be allowed to reclaim from the government the cost of providing up to two weeks of coronavirus-related SSP payments per employee. Further details on how employers can access the rebate will be provided in due course.
Thirdly, coronavirus has now been listed as a “notifiable disease” in England and Wales (following on from Scotland which had already done so), helping businesses to recover compensation through their insurance policies due to any impact from the virus, subject to their specific policy wording.
Finally, the temporary emergency legislation to provide that SSP will be available from the first day of sickness absence is still awaited. It is anticipated though that it will only extend to coronavirus-related absences and will not extend to sickness absences for other ill-health reasons.
The current rate of SSP is £94.25 per week and it will increase to £95.85 per week from 6 April 2020. However, those employees who earn less than £118 per week (rising to £120 per week from 6 April 2020) do not qualify for it.
For more information, Book a Free Consultation
Need Accountancy Support?
For information on bespoke training, or if you have any other questions for Makesworth Accountant, please fill in your details below













 151
151